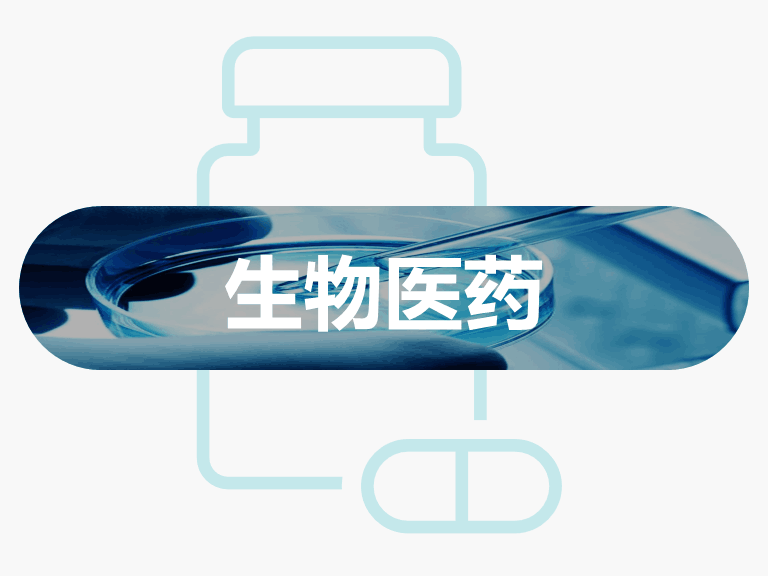

生物医疗与食品
极猎科技咨询的生物医疗与食品科技业务涵盖:生物医药、医疗器械和食品与饮品
由于生物技术的迅猛发展、民众医药消费结构的变化以及药物本身的安全性能要求,生物类新兴药物在药品市场中迅速崛起,同时越来越多的智能技术被应用于药物研发中,为生物医药产业带来了新的创新机遇。极猎科技咨询的学者团队通过对科技文献、专利、临床试验的广泛检索和分析,帮助企业在疫苗、生物制药、3D打印药物、AI制药等新兴领域获取前沿科研信息和临床结果,匹配合适的外部合作伙伴,助力您的新药研发。

医疗器械属于医疗系统的基础设施构成部分。近年来,我国在医疗器械领域的有效专利数逐年提升,国产替代进口是大势所趋。在当今技术变革医疗的大时代,全面实现医疗器械智能化,很大程度依赖于关键的生物医用材料和传感器技术。极猎科技咨询专长在仿生医用材料、可生物降解/吸收医用材料、植入器械封装、灭菌、消毒和储存技术、柔性可穿戴医疗设备、医用传感器技术等领域为企业挖掘适配产品、透视产品背后的技术积累、预测技术和市场趋势,帮助企业实现产品升级。

膳食是仅次于遗传而影响人类健康的第二大因素,人们对于食品的需求已经从基本的“保障供给”向“健康营养”转变。极猎科技咨询通过在营养学、农业、生物、化学、材料、先进制造等学科的交叉领域的广泛搜索和筛选,助力食品企业开发绿色、活菌食品、代餐、代糖、人造肉、天然食品防腐保鲜等创新商业模式和技术,实现食品制造的个性化、智能化和安全化。


